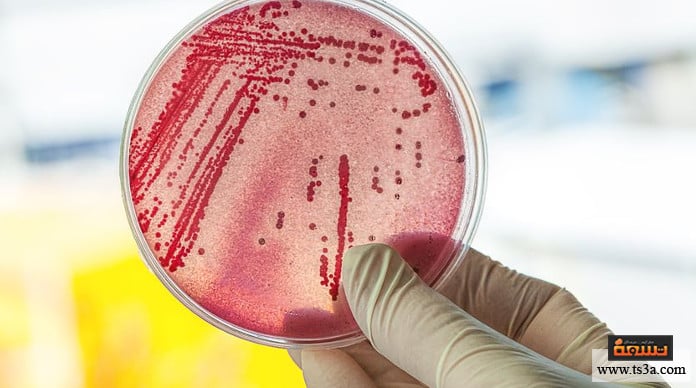

تنشأ فطريات المعدة نتيجة الإصابة بنوع من أنواع البكتريا، والتي تسبب التهاب القولون في البداية ثم تؤدي لوجود فطريات بالمعدة، ومن المعروف أن هناك نوعين من البكتريا الموجودة في الجهاز الهضمي، منها ما هو نافع ويفيد صحة الجهاز الهضمي والأمعاء، ومنها ما هو ضار والذي يتسبب في حدوث خلل في وظائف بعض أعضاء جسم الإنسان الداخلية، مما يترتب عليه الإصابة بالعديد من المشكلات الصحية منها اضطرابات المعدة والأمعاء، وقد تؤدي هذه البكتريا في حالات كثيرة إلى الإصابة بالسمنة نظرا لتأثيرها السلبي على عملية الهضم، ويعد فطر الكانديدا واحدا من أكثر أنواع الفطريات شيوعا وانتشارا، والتي تصيب المعدة والتي يزداد نشاطها بسبب نوع من البكتريا الضارة.
فطريات المعدة عند الرضع

يعد فطر الكانديدا من الفطريات الموجودة طبيعيا في الفم والجهاز الهضمي سواء بالنسبة للرضع والأطفال أو الكبار، ولكن عندما تضعف كفاءة الجهاز المناعي لدى الطفل تتزايد هذه الفطريات وتنتشر مما يؤدي لمرض المبيضات أو القلاع، وغالبا يكون هذا بسبب ارتداء الطفل للحفاضات التي تؤدي لرطوبة جلد الطفل في هذه المنطقة، وأيضا فقد ينتج أحيانا بسبب الإفراط في تناول المضادات الحيوية لأنها تتسبب في زيادة نشاط هذه البكتريا وزيادة إنتاجها لتفوق المعدل الطبيعي، وعلاوة على ذلك فإن فطر الكانديدا يتسبب في القضاء على البكتريا النافعة التي تلعب دورا رئيسيا في تقوية مناعة الجسم.
وتظهر أعراض فطر الكانديدا في عدة مناطق وفقا لمكان انتشارها بالجسم، فعند انتشارها في الجهاز الهضمي يبدأ ظهور الفطريات على لسان الطفل أو فمه في صورة بقع بيضاء اللون، وقد ينتشر هذا الطفح في خدود الطفل من الداخل، ويصاحب هذه الأعراض إصابة الطفل بالألم في أماكن البقع وقد يعاني من تشققات وجروح بسيطة في الفم، وكذلك يعاني من آلام بالحلق مع حرقة دائمة، وعند انتشار هذا الفطر في الجهاز البولي للطفل فيظهر على هذه المنطقة طفح جلدي واحمرار شديد، وكذلك يعاني الطفل من الحكة والحرقة والألم في هذه المنطقة، وقد يصاب الطفل بهذا الفطر بين ثنايا الجلد والسرة وتؤدي لوجود بقع حمراء في تلك المناطق بجانب الشعور بالحكة والحرقة في هذه المناطق.
فطريات المعدة عند الأطفال
قد يصاب الأطفال بفطريات المعدة نتيجة لعدة أسباب، أولها هو حدوث الإصابة بالتهابات القولون مما يؤدي لانتشار الفطريات بالمعدة، وكذلك فقد يكون السبب هو كثرة تناول الطفل للمضادات الحيوية وخصوصا أنواع المضادات التي تحتوي على نسبة من الكورتيزون، وكذلك فقد يصاب الطفل بهذه المشكلة نتيجة تعرضه لضغوطات نفسية وعصبية في المنزل، أو نتيجة لاضطرابات الهرمونات باختلاف مراحل النمو، وتبدأ ظهور بعض الأعراض على الطفل مثل تراجع الشهية للطعام مع الإقبال على الأطعمة النشوية والسكريات، والشكوى من آلام البطن والإصابة بالإمساك أو الإسهال والانتفاخات، وكذلك انخفاض الطاقة والشعور بالإجهاد المستمر، وأيضا ضعف القدرة على التركيز والشعور بالدوار، وكذلك فقد تنتج عنها بعض الأمراض الجلدية كالصدفية والإكزيما، ولا بد من الاهتمام بعلاج فطريات المعدة لتجنب حدوث المضاعفات، والتي تشمل صعوبة البلع والتهابات المريء والإصابة بالسمنة والحساسية ضد الطعام، وانتقال العدوى إلى بعض الأعضاء الداخلية والذي يمثل خطورة بالغة حيث ينتقل للكلى والدماغ والمفاصل والقلب، وكذلك الإصابة بمتلازمة الارتشاح في القناة الهضمية أو التسرب.
فطريات المعدة من نوع الكانديدا في الأمعاء
تختلف أسباب الإصابة بفطريات الكانديدا في الأمعاء، فقد يكون السبب هو وجود السموم وتراكمها بالأمعاء مما يؤدي لنمو الفطريات، وأيضا قد تحدث الإصابة به بسبب التعرض للتوتر والاضطرابات النفسية، وذلك لأن هذه الاضطرابات ينتج عنها حدوث خلل في الهرمونات فيزداد إفراز هرمون الكورتيزول مما يؤثر بالسلب على الجهاز المناعي ويضعفه، وينتج عن ذلك ارتفاع مستويات السكر في الدم وزيادة مقاومة الأنسولين فتصبح البيئة مناسبة لنمو الفطريات، وقد يكون السبب هو وجود خلل في الغدة الدرقية وإفرازها للهرمونات، مما يضعف الجهاز المناعي أيضا ويؤثر على مستويات السكر في الدم.
وأيضا فإن حبوب منع الحمل قد تؤدي للإصابة بالكانديدا نظرا لما تسببه في اضطراب هرمونات الجسم، وكذلك عند تناول بعض الأدوية مثل المضادات الحيوية وأدوية الربو حيث أن لها تأثيرا سلبيا على الجهاز المناعي، وأيضا العلاج الكيميائي لمرضى السرطان وعلاجات الإيدز كلاهما يضعف مناعة الجسم، وعلاوة على ذلك فإن النظام الغذائي غير الصحي يؤدي للإصابة بالكانديدا، وخصوا عند الإفراط في تناول الكربوهيدرات والسكريات وذلك لأن هذه الفطريات تتغذى على هذه المواد وتتكاثر، وأخيرا فإن كثرة تناول الكحوليات ونقص حموضة المعدة عن المستوى الطبيعي كلاهما يوفر بيئة جيدة لنمو البكتريا الضارة في الأمعاء.
علاج فطريات الكانديدا
يحتاج علاج هذه الفطريات إلى إتباع بعض الخطوات ففي البداية لا بد من تناول الأدوية المضادة للفطريات من أجل القضاء على هذه الفطريات والتخلص منها قدر الإمكان، ومن الممكن استخدام زيت البردقوش من أجل ذلك فهو يعمل كمضاد حيوي طبيعي ضد الفطريات الضارة، ولا بد أيضا من تناول الأدوية لتعزيز نمو البكتريا الجيدة في الجسم، وبالإضافة إلى ذلك فلا بد من الاهتمام بتعديل النظام الغذائي بإتباع نظاما صحيا، عن طريق تقليل السكريات ومنتجات الألبان والأطعمة المصنعة والسكريات، والإكثار من الخضروات والألياف والأحماض الصحية، وكذلك تناول مكملات فيتامين ب12 أو الأطعمة الغنية به كاللحوم الحمراء والأسماك والبيض، ولا بد أيضا من ممارسة الرياضة وشرب كميات جيدة من الماء من أجل تحسين عملية التمثيل الغذائي في الجسم.
علاج فطريات المعدة
يمكن علاج فطريات المعدة والأمعاء عن طريق بعض الأطعمة والمشروبات التي تقوم بقتل هذه الفطريات، مثل الثوم والذي يعد مضادا حيويا طبيعيا للفطريات والبكتريا، وذلك بتناول فص من الثوم يوميا على الريق مع كوب من الماء الساخن، وأيضا يعد العسل من أفضل المواد الطبيعية المطهرة للجسم، حيث يتم عمل مزيج مكون من ملعقتان من العسل وملعقتان من الماء الدافيء، ثم يتم تناول هذا المزيج ثلاث مرات يوميا، ويمكن أيضا استخدام الخل لقتل الفطريات فهو أيضا ذو خصائص مطهرة ومضادة للفطريات، حيث نقوم بوضع ملعقة من الخل في كوب من الماء الدافيء ويتم تناول هذا المزيج عدة مرات يوميا، كما يمكن أيضا تناول كوب من مشروب الزنجبيل عدة مرات يوميا لما له من تأثير فعال في القضاء على الفطريات وتنظيف الجسم من السموم، حيث نقوم بوضع ملعقة من الزنجبيل المطحون في كوب من الماء المغلي ثم يترك 10 دقائق وبعدها يتم شربه.
فطريات المعدة والأمعاء هي من المشكلات التي تصيب الأطفال والكبار على حد السواء، وهي تحدث بسبب ضعف الجهاز المناعي مما يؤدي لنمو هذه الفطريات وانتشارها، ومن أشهر هذه الفطريات هو فطر الكانديدا والتي تظهر أعراضه بالإصابة باضطرابات في الجهاز الهضمي، وأيضا الإمساك والإسهال والانتفاخات وغيرها من الأعراض، ويمكن علاج الفطريات عن طريق تناول مضادات الفطريات وتقوية مناعة الجسم بأدوية المناعة، كما يمكن استخدام بعض العناصر الطبيعية لمحاربة الفطريات مثل الثوم والخل والعسل والزنجبيل.
ملحوظة: هذا المقال يحتوي على نصائح طبية، برغم من أن هذه النصائح كتبت بواسطة أخصائيين وهي آمنة ولا ضرر من استخدامها بالنسبة لمعظم الأشخاص العاديين، إلا أنها لا تعتبر بديلاً عن نصائح طبيبك الشخصي. استخدمها على مسئوليتك الخاصة.


